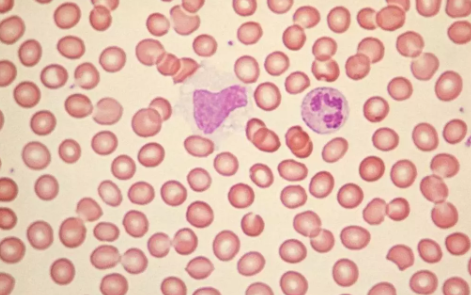
小孩淋巴結腫大的食療方法 小孩淋巴結腫大不能吃什么

時間:2019-05-07 17:06:24來源:本站整理作者:zl點擊:
家長在給孩子檢查淋巴結之后都會對孩子的吃食更加關心,希望從食物上給寶寶補充營養,預防淋巴結腫脹,下面八寶網的小編就帶來:小孩淋巴結腫大的食療方法 小孩淋巴結腫大不能吃什么。

小孩淋巴結腫大宜吃抗菌消炎消腫的食物 如蒲公英、魚腥草、海帶、芋艿、慈姑、荸薺;以及富含優質蛋白質,維生素的食物,如荔枝、檸檬、蘋果、牛奶、雞蛋、白菜;
小孩淋巴結腫大忌吃辛辣刺激的食物 如辣椒、生姜、花椒以及油炸的食物,如薯條、麻花。
馬齒莧薏米茶
炒熟的薏米仁、芡實、赤小豆各5克用冷水浸泡一夜,洗凈后加水,小火煮一小時,再加入馬齒莧、淡竹葉各1克,煮半小時,待涼飲用。
功效:有清熱、健脾、排毒的作用。
或取海蜇皮(漂凈)30克,鮮荸薺120克,加水煮30分鐘服用,有化痰,清熱,消腫的作用。

淋巴結腫大在兒童耳后、頸部非常常見。一般一至數個可滑動的無壓痛的蠶豆大小的淋巴結多位于耳后、乳突區、枕下及頸后區域,多無明顯實際意義,無需特殊治療。
有壓痛的淋巴結多為感染所致的急性淋巴結腫大,感染控制后會縮小甚至消失。
如果腫大淋巴結伴有局部皮膚紅腫、有波動感,說明局部可能形成膿腫,此時可考慮手術切開引流。
若淋巴結固定、不移動,說明其與周圍組織有粘連,此時需進一步明確原因。
如果淋巴結腫大越來越嚴重、數目越來越多、無壓痛感、摸上去較硬或活動度不好者應及時檢查排除淋巴瘤、白血病及其他惡性腫瘤的淋巴結轉移。
網友跟帖
Copyright 2015-2020 8bb.com 〖八寶網〗 版權所有 鄂ICP備19016373號-1
聲明: 本站文章均來自互聯網,不代表本站觀點 如有異議 請與本站聯系 本站為非贏利性網站 不接受任何贊助和廣告
網友評論僅供其表達個人看法,并不表明八寶網立場。